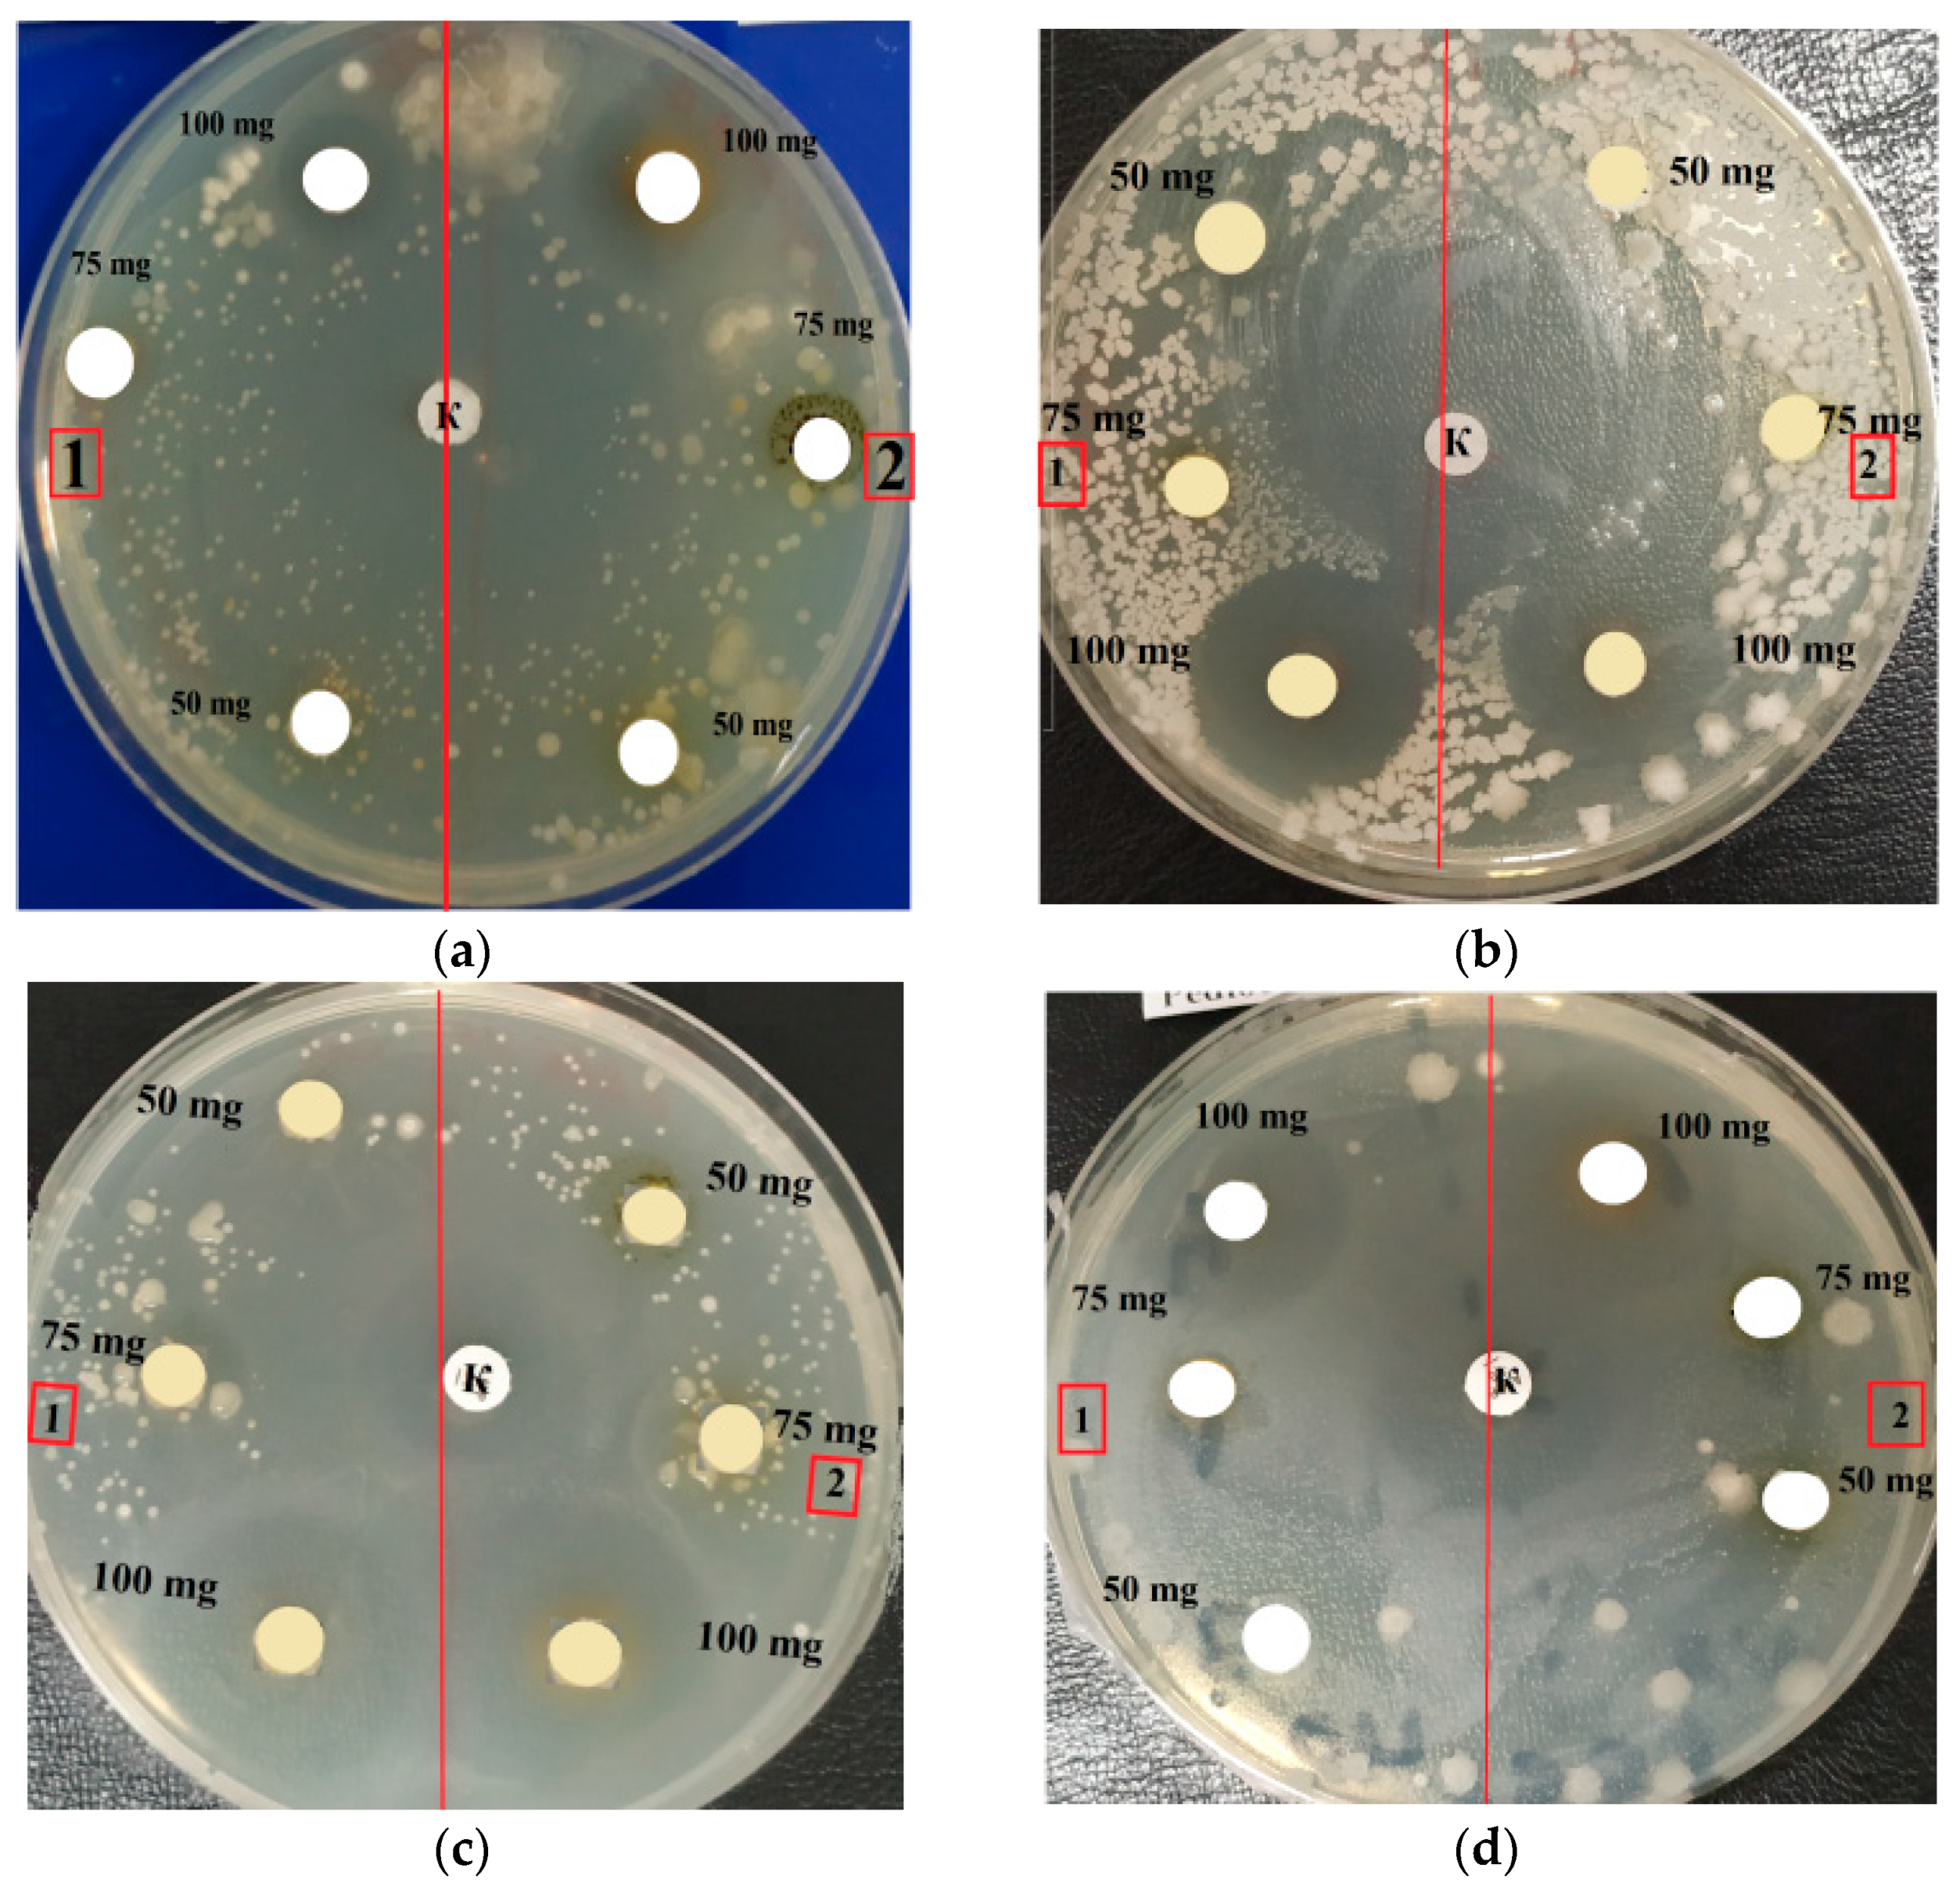
Molecules 27 05871 g003

Study of the Physicochemical and Biological Properties of the Lipid Complex of Marine Microalgae Isolated from the Coastal Areas of the Eastern Water Area of the Baltic Sea
Abstract
:1. Introduction
2. Results
2.1. Isolate Identification
2.2. Physicochemical Properties of Microalgae
2.3. Antimicrobial Activity
2.4. Minimum Inhibitory Concentration (MIC)
2.5. Determination of the Cytotoxicity of Lipid Complexes of Microalgae
2.6. Determination of Antioxidant Properties of Lipid Complexes of Microalgae
3. Discussion
4. Materials and Methods
4.1. Materials
4.2. Microalgae Samples
4.3. Investigation of the Physicochemical Properties of Microalgae
4.4. Extraction of Lipids
4.5. Purification of the Microalgae Lipid Complex
4.6. GC-MS Analysis
4.7. Antibiotic Activity by Disc Diffusion Test
4.8. Minimum Inhibitory Concentration
4.9. Lipid Complex Cytotoxicity
4.10. Antioxidant Activity of Microalgae Lipid Complexes
4.11. Statistical Analysis
5. Conclusions
Author Contributions
Funding
Institutional Review Board Statement
Informed Consent Statement
Data Availability Statement
Conflicts of Interest
Appendix A


References
- Rizwan, M.; Mujtaba, G.; Memon, S.A.; Lee, K.; Rashid, N. Exploring the potential of microalgae for new biotechnology applications and beyond: A review. Renew. Sustain. Energy Rev. 2009, 92, 394–404. [Google Scholar] [CrossRef]
- Villarruel-Lopez, A.; Ascencio, F.; Nuno, K. Microalgae, a Potential Natural Functional Food Source—A Review. Pol. J. Food Nutr. Sci. 2017, 67, 251–263. [Google Scholar] [CrossRef]
- Vorobyev, V.V. Microalgae are promising resources for the development of bioenergy (review). Agrar. Ross. 2016, 1, 2–7. (In Russian) [Google Scholar] [CrossRef]
- El-Naggar, N.E.A.; Hussein, M.H.; Shaaban-Dessuuki, S.A.; Dalal, S.R. Production, extraction and characterization of Chlorella vulgaris soluble polysaccharides and their applications in AgNPs biosynthesis and biostimulation of plant growt. Sci. Rep. 2020, 10, 3011. [Google Scholar] [CrossRef]
- Sambit, S.; Mriganka, S.M.; Tridib, K.B.; Kalyan, G. Priority-based multiple products from microalgae: Review on techniques and strategies. Crit. Rev. Biotech. 2020, 40, 590–607. [Google Scholar] [CrossRef]
- Abdelillah, A.; Houcine, B.; Halima, D.; sari Meriem, C.; Imane, Z.; Eddine, S.D.; Abdallah, M.; sari Daoudi, C. Evaluation of antifungal activity of free fatty acids methyl esters fraction isolated from Algerian Linum usitatissimum L. seeds against toxigenic Aspergillus. Asian Pac. J. Trop. Biomed. 2013, 3, 443–448. [Google Scholar] [CrossRef]
- Barka, A.; Blecker, C. Microalge as a potential source of singelcell proteins. A review. Biotech. Agron. Soc. Environ. 2016, 20, 27–436. [Google Scholar]
- Stepanova, E.M.; Lugovaya, E.A. Macro- and microelements in some species of marine life from the Sea of Okhotsk. Foods Raw Mater. 2021, 9, 302–309. [Google Scholar] [CrossRef]
- Xie, T.; Xia, Y.; Zeng, Y.; Li, X.; Zhang, Y. Nitrate concentration-shift cultivation to enhance protein content of heterotrophic microalga Chlorella vulgaris: Over-compensation strategy. Bioresour. Technol. 2017, 233, 247–255. [Google Scholar] [CrossRef]
- Waghmare, A.G.; Salve, M.K.; LeBlanc, J.G.; Arya, S.S. Concentration and characterization of microalgae proteins from Chlorella pyrenoidosa. Bioresour. Bioprocess 2016, 3, 16. [Google Scholar] [CrossRef]
- Babich, O.; Sukhikh, S.; Prosekov, A.; Asyakina, L.; Ivanova, S. Medicinal Plants to Strengthen Immunity during a Pandemic. Pharmaceuticals 2020, 13, 313. [Google Scholar] [CrossRef] [PubMed]
- Amorim, M.L.; Soares, J.; dos Reis Coimbra, J.S.; de Oliveira Leite, M.; Teixeira Albino, L.F.; Martins, M.A. Microalgae proteins: Production, separation, isolation, quantification, and application in food and feed. Crit. Rev. Food Sci. Nutr. 2020, 61, 1976–2002. [Google Scholar] [CrossRef] [PubMed]
- Kai Ru, I.T.; Sung, Y.Y.; Jusoh, M.; Abdul Wahid, M.E.; Nagappan, T. Chlorella vulgaris: A perspective on its potential for combining high biomass with high value bioproducts. J. Appl. Physiol. 2020, 1, 2–11. [Google Scholar] [CrossRef]
- Vernèsa, L.; Abert-Viana, M.; El Maâtaouib, M.; Taoc, Y.; Bornardd, I.; Chemata, F. Application of ultrasound for green extraction of proteins from spirulina. Mechanism, optimization, modeling, and industrial prospects. Ultrason. Sonochem. 2019, 54, 48–60. [Google Scholar] [CrossRef]
- Chia, S.R.; Chew, K.W.; Zaid, H.F.M.; Chu, D.-T.; Tao, Y.; Show, P.L. Microalgal Protein Extraction from Chlorella vulgaris FSP-E Using Triphasic Partitioning Technique with Sonication. Front. Bioeng. Biotechnol. 2019, 7, 396. [Google Scholar] [CrossRef]
- Chewa, K.W.; Chiaa, S.R.; Leeb, S.Y.; Liandong, Z.; Pau-Loke, S. Enhanced microalgal protein extraction and purification using sustainable microwave-assisted multiphase partitioning technique. Chem. Eng. J. 2019, 367, 1–8. [Google Scholar] [CrossRef]
- Scharff, C.; Domurath, N.; Wensch-Dorendorf, M.; Schröder, F.-G. Effect of different photoperiods on the biochemical profile of the green algae C. vulgaris and S. obliquus. In Proceedings of the International Symposium on New Technologies and Management for Greenhouses-GreenSys2015, Evora, Portugal, 19–23 July 2015; ISHS Acta Horticulturae: Leuven, Belgium, 2017; Volume 1170, pp. 1149–1156. [Google Scholar] [CrossRef]
- Nesterova, S.V.; Shapoval, O.G.; Anokhina, T.V. Comparative evaluation of the antibacterial activity of two antiseptics in vivo and in vitro. Int. Stud. Sci. Bull. 2018, 1. Available online: https://eduherald.ru/ru/article/view?id=18113 (accessed on 16 July 2022).
- Alsenani, F.; Tupally, K.R.; Chua, E.T.; Eltanahy, E.; Alsufyani, H.; Harendra, S.P. Evaluation of microalgae and cyanobacteria as potential sources of antimicrobial compounds. Saudi Pharm. J. 2020, 12, 1834–1841. [Google Scholar] [CrossRef]
- Manilal, A.; Sujith, S.; Selvin, J.; Shakir, C.; Kiran, G.S. Antibacterial activity of Falkenbergia hillebrandii (Born) from the Indian coast against human pathogens. Phyton 2009, 78, 161–166. [Google Scholar]
- Omar, H.; Shiekh, H.; Gumgumjee, N.; El-Kazan, M.; El-Gendy, A. Antibacterial activity of extracts of marine algae from the Red Sea of Jeddah, Saudi Arabia. Afr. J. Biotechnol. 2012, 11, 13576–13585. [Google Scholar] [CrossRef]
- Little, S.M.; Senhorinho, G.N.A.; Saleh, M.; Basiliko, N.; Scott, J.A. Antibacterial compounds in green microalgae from extreme environments: A review. Algae 2021, 36, 61–72. [Google Scholar] [CrossRef]
- Govindarajan, R.; Shukla, S.; Marappan, M.; Thirumalaiselvan, S.; Sudhagar, A.; Kothari, D.C.; Singh, A. Antibacterial Activity of Spirulina (Arthospira platensis Geitler) against Bacterial Pathogens in Aquaculture. Isr. J. Aquac. 2013, 932, 65. [Google Scholar] [CrossRef]
- Kandula, S.K.; Haritha, R.; Mohan, Y.S.Y.V. Screening of Marine Actinobacteria for Antimicrobial Compounds. Res. J. Microbiol. 2011, 6, 385–393. [Google Scholar] [CrossRef]
- Zielinski, D.; Fraczyk, J.; Debowski, M.; Zielinski, M.; Kaminski, Z.J.; Kregiel, D.; Jacob, C.; Kolesinska, B. Biological Activity of Hydrophilic Extract of Chlorella vulgaris Grown on Post-Fermentation Leachate from a Biogas Plant Supplied with Stillage and Maize Silage. Molecules 2020, 25, 1790. [Google Scholar] [CrossRef] [PubMed]
- Selivanova, E.A.; Ignatenko, M.E.; Nemtseva, N.V. Antagonistic activity of novel green microalgae strain. J. Microbiol. Epidemiol. Immunobiol. 2014, 4, 72–76. (In Russian) [Google Scholar]
- Pina-Pérez, M.C.; Rivas, A.; Martínez, A.; Rodrigo, D. Antimicrobial potential of macro and microalgae against pathogenic and spoilage microorganisms in food. Food Chem. 2017, 235, 34–44. [Google Scholar] [CrossRef]
- Dupré, C.; Burrows, H.D.; Campos, M.G.; Delattre, C.; Encarnação, T.; Fauchon, M.; Gaignard, C.; Hellio, C.; Ito, J.; Laroche, C.; et al. Microalgal Biomass of Industrial Interest: Methods of Characterization. In Handbook on Characterization of Biomass, Biowaste and Related By-Products; Nzihou, A., Ed.; Springer: Cham, Switzerland, 2020; pp. 537–639. [Google Scholar]
- Dolganyuk, V.; Belova, D.; Babich, O.; Prosekov, A.; Ivanova, S.; Katserov, D.; Patyukov, N.; Sukhikh, S. Microalgae: A Promising Source of Valuable Bioproducts. Biomolecules 2020, 10, 1153. [Google Scholar] [CrossRef]
- Khammee, P.; Ramaraj, R.; Whangchai, N.; Prakash, B.; Yuwalee, U. The immobilization of yeast for fermentation of macroalgae Rhizoclonium sp. for efficient conversion into bioethanol. Biomass Convers. Bioref. 2021, 11, 827–835. [Google Scholar] [CrossRef]
- Anandhan, S.; Kumari, H.S. Biorestraining Potentials of Marine Macroalgae Collected from Rameshwaram Tamilnadu. J. Res. Biol. 2011, 5, 385–392. [Google Scholar]
- Ozkan, A.; Berberoglu, H. Physico-chemical surface properties of microalgae. Colloids Surf. B 2013, 112, 287–293. [Google Scholar] [CrossRef]
- German-Báez, L.J.; Valdez-Flores, M.A.; Félix-Medina, J.V.; Norzagaray-Valenzuela, C.D.; Santos-Ballardo, D.U.; Reyes-Moreno, C.; Shelton, L.M.; Valdez-Ortiz, A. Chemical composition and physicochemical properties of Phaeodactylum tricornutum microalgal residual biomass. Food Sci. Technol. Int. 2017, 28, 681–689. [Google Scholar] [CrossRef] [PubMed]
- Matin, P.; Hanee, U.; Alam, M.S.; Jeong, J.E.; Matin, M.M.; Rahman, M.R.; Mahmud, S.; Alshahrani, M.M.; Kim, B. Novel Galactopyranoside Esters: Synthesis, Mechanism, In Vitro Antimicrobial Evaluation and Molecular Docking Studies. Molecules 2022, 27, 4125. [Google Scholar] [CrossRef] [PubMed]
- Matin, M.M.; Chakraborty, P.; Alam, M.S.; Islam, M.M.; Hanee, U. Novel mannopyranoside esters as sterol 14α-demethylase inhibitors: Synthesis, PASS predication, molecular docking, and pharmacokinetic studies. Carbohydr. Res. 2020, 496, 108130. [Google Scholar] [CrossRef] [PubMed]
- Muhammad, D.; Matin, M.; Miah, S.; Devi, P. Synthesis, Antimicrobial, and DFT Studies of Some Benzyl 4-O-Acyl-α-L-rhamnopyranosides. Orbital Electron. J. Chem. 2021, 13, 250–258. [Google Scholar] [CrossRef]
- Sarat Chandra, T.; Aditi, S.; Maneesh Kumar, M.; Mukherji, S.; Modak, J.; Chauhan, V.S.; Sarada, R.; Mudliar, S.N. Growth and biochemical characteristics of an indigenous freshwater microalga, Scenedesmus obtusus, cultivated in an airlift photobioreactor: Effect of reactor hydrodynamics, light intensity, and photoperiod. Bioprocess Biosyst. Eng. 2017, 40, 1057–1068. [Google Scholar] [CrossRef]
- Avula, S.G.C.; Belovich, J.M.; Xu, Y. Determination of fatty acid methyl esters derived from algae Scenedesmus dimorphus biomass by GC–MS with one-step esterification of free fatty acids and transesterification of glycerolipids. J. Sep. Sci. 2017, 40, 2214–2227. [Google Scholar] [CrossRef]
- Niemi, C.; Lage, S.; Gentili, F.G. Comparisons of analysis of fatty acid methyl ester (FAME) of microalgae by chromatographic techniques. Algal Res. 2019, 39, 101449. [Google Scholar] [CrossRef]
- Ramola, B.; Kumar, V.; Nanda, M.; Mishra, Y.; Tyagi, T.; Gupta, A.; Sharma, N. Evaluation, comparison of different solvent extraction, cell disruption methods and hydrothermal liquefaction of Oedogonium macroalgae for biofuel production. Biotechnol. Rep. 2019, 22, e00340. [Google Scholar] [CrossRef]
- Sprague, M.; Betancor, M.B.; Tocher, D.R. Microbial and genetically engineered oils as replacements for fish oil in aquaculture feeds. Biotechnol. Lett. 2017, 39, 1599–1609. [Google Scholar] [CrossRef]
- Ferreira, G.F.; Ríos Pinto, L.F.; Maciel Filho, R.; Fregolente, L.V. A review on lipid production from microalgae: Association between cultivation using waste streams and fatty acid profiles. Renew. Sustain. Energy Rev. 2019, 109, 448–466. [Google Scholar] [CrossRef]
- Noskova, S.; Moroz, N.; Sukhikh, S.; Zimina, M.; Prosekov, A.; Voblikova, T. The study of antibacterial, fungicidal and cytotoxic properties of antagonist microorganisms. In IOP Conference Series: Earth and Environmental Science; IOP Publishing: Bristol, UK, 2020; Volume 613, p. 012095. [Google Scholar] [CrossRef]
- Costa, N.C.S.; Piccoli, J.P.; Santos-Filho, N.A.; Clementino, L.C.; Fusco-Almeida, A.M.; de Annunzio, S.R.; Fontana, C.R.; Verga, J.B.M.; Eto, S.F.; Pizauro-Junior, J.M.; et al. Antimicrobial activity of RP-1 peptide conjugate with ferrocene group. PLoS ONE 2020, 15, e0228740. [Google Scholar] [CrossRef] [PubMed]
- Van Meerloo, J.; Kaspers, G.J.; Cloos, J. Cell sensitivity assays: The MTT assay. Methods Mol. Biol. 2011, 731, 237–245. [Google Scholar] [CrossRef] [PubMed]
- Eskandani, M.; Hamishehkar, H.; Ezzati Nazhad Dolatabadi, J. Cytotoxicity and DNA damage properties of terttylhydroquinone (TBHQ) food additive. Food Chem. 2014, 153, 315–320. [Google Scholar] [CrossRef] [PubMed]
- Strober, W. Trypan blue exclusion test of cell viability. Curr. Protoc. Immunol. 2015, 111, A3B1–A3B3. [Google Scholar] [CrossRef]
- Cohen, J.J. Apoptosis. Immunol. Today 1993, 14, 126–130. [Google Scholar] [CrossRef]

| Indicator | Microalgae | |
|---|---|---|
| C. vulgaris | A. platensis | |
| Duration of cultivation, days | 7 | 7 |
| Optical density (OD750) | 0.59 ± 0.01 | 0.86 ± 0.02 |
| pH | 8.7 ± 0.25 | 11.6 ± 0.34 |
| Density, kg/m3 | 909.34 ± 27.42 | 928.48 ± 27.75 |
| Dynamic viscosity, 10−3 Pa·s | 1.13 ± 0.03 | 0.96 ± 0.02 |
| Dry matter content,% | 0.49 ± 0.01 | 0.59 ± 0.01 |
| Color | green | green |
| Odor | faint herbaceous | faint herbaceous |
| Lipids, % | Microalgae | |
|---|---|---|
| C. vulgaris | A. platensis | |
| Neutral lipids | 37.1 ± 0.5 | 59.3 ± 0.9 |
| Triacylglycerides | 13.4 ± 0.4 | 28.7 ± 0.4 |
| Fatty acids | 24.3 ± 0.2 * | 27.9 ± 0.4 * |
| Polar lipids 1 | 0.9 ± 0.1 * | 1.1 ± 0.2 * |
| Unsaponifiable substances | 14.1 ± 0.2 | 18.4 ± 0.4 |
| Chlorophyllides 2 | 16.3 ± 0.1 | 6.3 ± 0.2 |
| Other impurities 3 | 57.9 ± 0.8 | 16.2 ± 0.3 |
| Content, mg/g | Microalgae | |
|---|---|---|
| C. vulgaris | A. platensis | |
| Myristic acid | 0.21 ± 0.1 | 0.14 ± 0.1 |
| Palmitic acid | 4.13 ± 0.2 * | 6.39 ± 0.2 * |
| Oleic acid | 6.64 ± 0.2 | 5.33 ± 0.2 |
| Stearic acid | 11.68 ± 0.2 | 11.16 ± 0.2 |
| Linoleic acid | 3.72 ± 0.2 | 3.95 ± 0.2 |
| Sample | Concentration of the Lipid Complex, μg/disc | ||
|---|---|---|---|
| 5.0 | 7.5 | 10.0 | |
| Control | 20.0 ± 0.15 a | 20.0 ± 0.15 a | 20.0 ± 0.15 a |
| E. coli | 6.1 ± 0.13 b | 16.3 ± 0.23 b | 17.0 ± 0.47 b |
| B. pumilus | 6.2 ± 0.23 b | 14.9 ± 0.13 b | 16.0 ± 0.27 b |
| L. mesenteroides | 6.6 ± 0.14 b | 14.5 ± 0.15 b | 17.0 ± 0.65 b |
| P. pentosaceus | 6.6 ± 0.24 b | 15.5 ± 0.23 b | 18.0 ± 0.45 ab |
| Sample | Concentration of the Lipid Complex, μg/disc | ||
|---|---|---|---|
| 5.0 | 7.5 | 10.0 | |
| Control | 20.0 ± 0.15 a | 20.0 ± 0.15 a | 20.0 ± 0.15 a |
| E. coli | 7.0 ± 0.23 b | 14.4 ± 0.45 b | 17.0 ± 0.21 b |
| B. pumilus | 8.0 ± 0.14 b | 14.0 ± 0.15 b | 16.0 ± 0.22 b |
| L. mesenteroides | 7.6 ± 0.14 b | 15.6 ± 0.23 b | 18.0 ± 0.24 ab |
| P. pentosaceus | 6.3 ± 0.36 b | 15.2 ± 0.12 b | 18.0 ± 0.45 ab |
| Lipid Complex | Antioxidant Activity, mg AA/g |
|---|---|
| C. vulgaris | 45.92 ± 0.77 |
| A. platensis | 45.85 ± 0.77 |
Publisher’s Note: MDPI stays neutral with regard to jurisdictional claims in published maps and institutional affiliations. |
© 2022 by the authors. Licensee MDPI, Basel, Switzerland. This article is an open access article distributed under the terms and conditions of the Creative Commons Attribution (CC BY) license (https://creativecommons.org/licenses/by/4.0/).
Share and Cite
Dolganyuk, V.; Andreeva, A.; Sukhikh, S.; Kashirskikh, E.; Prosekov, A.; Ivanova, S.; Michaud, P.; Babich, O. Study of the Physicochemical and Biological Properties of the Lipid Complex of Marine Microalgae Isolated from the Coastal Areas of the Eastern Water Area of the Baltic Sea. Molecules 2022, 27, 5871. https://doi.org/10.3390/molecules27185871
Dolganyuk V, Andreeva A, Sukhikh S, Kashirskikh E, Prosekov A, Ivanova S, Michaud P, Babich O. Study of the Physicochemical and Biological Properties of the Lipid Complex of Marine Microalgae Isolated from the Coastal Areas of the Eastern Water Area of the Baltic Sea. Molecules. 2022; 27(18):5871. https://doi.org/10.3390/molecules27185871
Chicago/Turabian StyleDolganyuk, Vyacheslav, Anna Andreeva, Stanislav Sukhikh, Egor Kashirskikh, Alexander Prosekov, Svetlana Ivanova, Philippe Michaud, and Olga Babich. 2022. "Study of the Physicochemical and Biological Properties of the Lipid Complex of Marine Microalgae Isolated from the Coastal Areas of the Eastern Water Area of the Baltic Sea" Molecules 27, no. 18: 5871. https://doi.org/10.3390/molecules27185871
APA StyleDolganyuk, V., Andreeva, A., Sukhikh, S., Kashirskikh, E., Prosekov, A., Ivanova, S., Michaud, P., & Babich, O. (2022). Study of the Physicochemical and Biological Properties of the Lipid Complex of Marine Microalgae Isolated from the Coastal Areas of the Eastern Water Area of the Baltic Sea. Molecules, 27(18), 5871. https://doi.org/10.3390/molecules27185871

